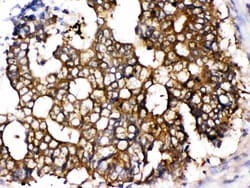
Invitrogen TCP1 epsilon Polyclonal Antibody 100 &mu;g; Unconjugated:Antibodies,

Learn More
Invitrogen™ TCP1 epsilon Polyclonal Antibody


Rabbit Polyclonal Antibody
Brand: Invitrogen™ PA578955
Description
Reconstitute with 0.2 mL of distilled water to yield a concentration of 500 μg/mL. Positive Control - WB: human Hela whole cell, human MCF-7 whole cell, human SiHa whole cell, human A549 whole cell, human 293T whole cell, human CACO-2 whole cell, human PC-3 whole cell, human U20S whole cell, rat testis tissue, mouse testis tissue, mouse liver tissue. IHC: mouse ovary tissue, rat ovary tissue, human intestinal cancer tissue. ICC/IF: U20S cell, LOVO Cell. Flow: A431 cell.
This gene encodes a molecular chaperone that is member of the chaperonin containing TCP1 complex (CCT), also known as the TCP1 ring complex (TRiC). This complex consists of two identical stacked rings, each containing eight different proteins. Unfolded polypeptides enter the central cavity of the complex and are folded in an ATP-dependent manner. The complex folds various proteins, including actin and tubulin. Alternate transcriptional splice variants of this gene have been observed but have not been thoroughly characterized.
Specifications
| TCP1 epsilon | |
| Polyclonal | |
| Unconjugated | |
| CCT5 | |
| CCT5; CCTE; CCT-epsilon; chaperonin containing TCP1 subunit 5; chaperonin containing Tcp1, subunit 5 (epsilon); chaperonin subunit 5 (epsilon); epididymis secretory protein Li 69; HEL-S-69; Kiaa0098; mKIAA0098; PNAS-102; T-complex protein 1 subunit epsilon; TCP-1 epsilon; TCP-1-epsilon; TCPE; unm tf212; unm_tf212; wu:fb54h08 | |
| Rabbit | |
| Antigen affinity chromatography | |
| RUO | |
| 12465, 22948, 294864 | |
| -20°C | |
| Lyophilized |
| Flow Cytometry, Immunohistochemistry (Paraffin), Western Blot, Immunocytochemistry, Western Blot | |
| 500 μg/mL | |
| PBS with 5mg BSA and 0.01mg sodium azide | |
| P48643, P80316, Q68FQ0 | |
| CCT5 | |
| E. coli-derived human CCT5 recombinant protein (Position: L443-K535). | |
| 100 μg | |
| Primary | |
| Human, Mouse, Rat | |
| Antibody | |
| IgG |
Your input is important to us. Please complete this form to provide feedback related to the content on this product.